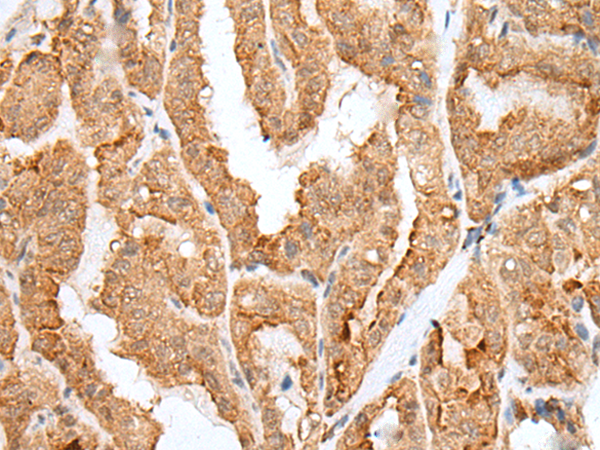

别名:HOX4H应用:IHC
反应种属:Human
规格:50μl/100μl
| Description |
|---|
| This gene belongs to the homeobox family of genes. The homeobox genes encode a highly conserved family of transcription factors that play an important role in morphogenesis in all multicellular organisms. Mammals possess four similar homeobox gene clusters, HOXA, HOXB, HOXC and HOXD, located on different chromosomes, consisting of 9 to 11 genes arranged in tandem. This gene is one of several homeobox HOXD genes located in a cluster on chromosome 2. Deletions that remove the entire HOXD gene cluster or the 5′ end of this cluster have been associated with severe limb and genital abnormalities. The exact role of this gene has not been determined. |
| Specification | |
|---|---|
| Aliases | HOX4H |
| Swissprot | P35452 |
| Host/Isotype | Rabbit IgG |
| Storage | Store at 4°C short term. Aliquot and store at -20°C long term. Avoid freeze/thaw cycles. |
| Species Reactivity | Human |
| Immunogen | Synthetic peptide of human HOXD12 |
| Formulation | pH7.4 PBS, 0.05% NaN3, 40% Glycerol |
| Application | |
|---|---|
| IHC | 1/25-1/100 |
| ELISA | 1/5000-1/10000 |
![]() |
The image is immunohistochemistry of paraffin-embedded Human colorectal cancer tissue using P12677(HOXD12 Antibody) at dilution 1/30. (Original magnification: ×200) |
![]() |
The image is immunohistochemistry of paraffin-embedded Human thyroid cancer tissue using P12677(HOXD12 Antibody) at dilution 1/30. (Original magnification: ×200) |
本公司的所有产品仅用于科学研究或者工业应用等非医疗目的,不可用于人类或动物的临床诊断或治疗,非药用,非食用。
暂无评论
本公司的所有产品仅用于科学研究或者工业应用等非医疗目的,不可用于人类或动物的临床诊断或治疗,非药用,非食用。
中文

发表回复